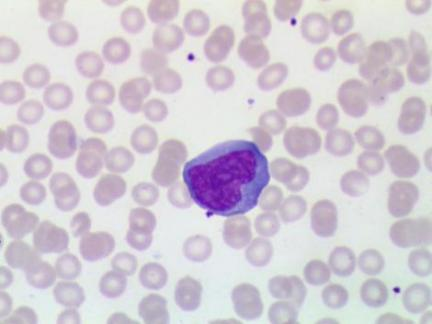

科普文章
如果爱我,请不要亲吻我
发布时间:2024-12-03 发布者: 健康教育科
676
分享到:

文图:检验科 魏园玉
审稿:王鹏
编辑:陈劼明
责编:刘芙蓉
审核:鲁美苏
医院地址:郑州市康复前街7号
母婴服务热线:0371-66903131
投稿反馈邮箱:zdsfyjkjyk@126.com
上一篇:
科普长图:职业病致残!你需要知道的事
下一篇:
消炎药是抗生素吗?